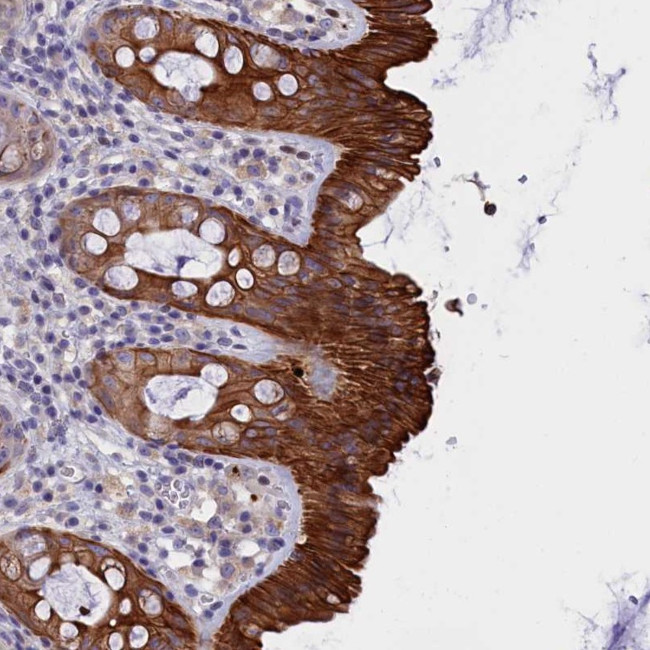
C16orf62 Antibody in Immunohistochemistry (Paraffin) (IHC (P))

Search
Invitrogen
C16orf62 Polyclonal Antibody
{{$productOrderCtrl.translations['antibody.pdp.commerceCard.promotion.promotions']}}
{{$productOrderCtrl.translations['antibody.pdp.commerceCard.promotion.viewpromo']}}
{{$productOrderCtrl.translations['antibody.pdp.commerceCard.promotion.promocode']}}: {{promo.promoCode}} {{promo.promoTitle}} {{promo.promoDescription}}. {{$productOrderCtrl.translations['antibody.pdp.commerceCard.promotion.learnmore']}}
产品信息
PA5-60178
种属反应
宿主/亚型
分类
类型
抗原
偶联物
形式
浓度
规格
纯化类型
保存液
内含物
保存条件
运输条件
RRID
产品详细信息
Immunogen sequence: ENNKLCETVM AQILEHLKTL AKDEALKRQS SLGLSFFNSI LAHGDLRNNK LNQLSVNLWH LAQRHGCADT RTMVKTLEYI KKQSKQPDMT HLTELA
Highest antigen sequence identity to the following orthologs: Mouse - 93%, Rat - 91%.
靶标信息
Acts as component of the retriever complex. The retriever complex is a heterotrimeric complex related to retromer cargo-selective complex (CSC) and essential for retromer-independent retrieval and recycling of numerous cargos such as integrin alpha-5/beta-1 (ITGA5:ITGB1) (PubMed:28892079). The recruitment of the retriever complex to the endosomal membrane involves CCC and WASH complexes (PubMed:28892079). In the endosomes, drives the retrieval and recycling of NxxY-motif-containing cargo proteins by coupling to SNX17, a cargo essential for the homeostatic maintenance of numerous cell surface proteins associated with processes that include cell migration, cell adhesion, nutrient supply and cell signaling (PubMed:28892079). Involved in copper-dependent ATP7A trafficking between the trans-Golgi network and vesicles in the cell periphery; the function is proposed to depend on its association with the CCC complex and cooperation with the WASH complex on early endosomes. Seems not to be required for CCC complex stability (PubMed:25355947). [UniProt]
仅用于科研。不用于诊断过程。未经明确授权不得转售。
篇参考文献 (0)
生物信息学
蛋白别名: esophageal cancer associated protein; Esophageal cancer-associated protein; unnamed protein product; UPF0505 protein C16orf62; VPS35 endosomal protein-sorting factor-like
基因别名: 101F10.2; C16orf62; EC97; RTSC3; VPS35L
UniProt ID: (Human) Q7Z3J2
Entrez Gene ID: (Human) 57020